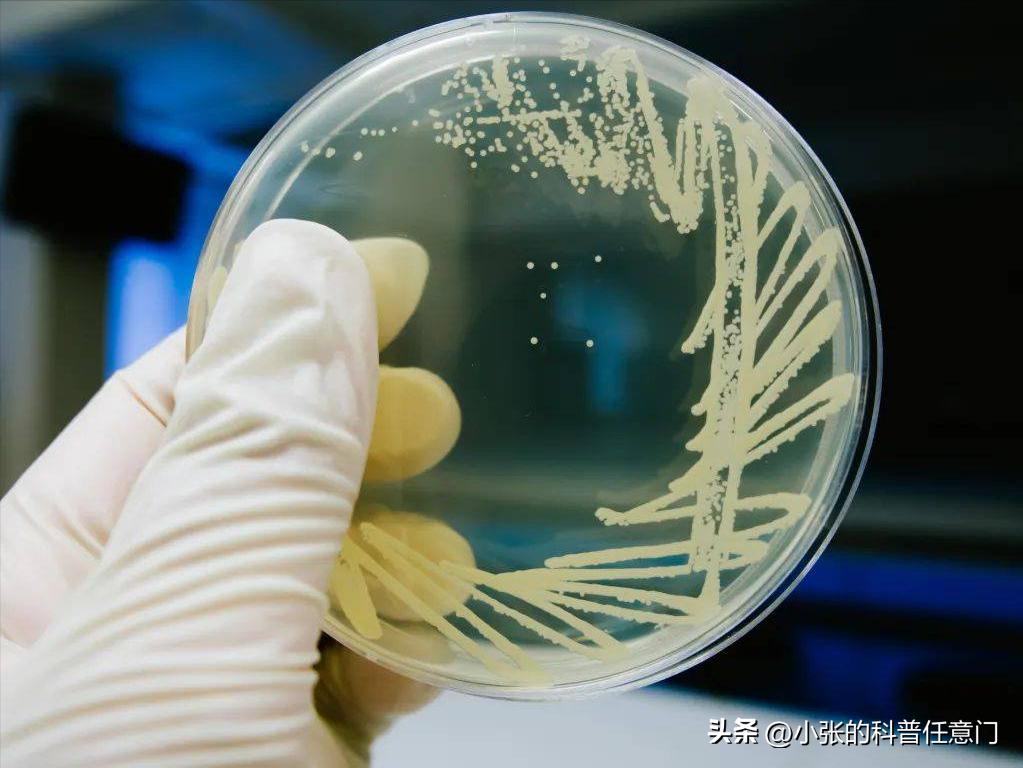
淫羊藿野生和种植效果有区别吗,淫羊藿根系

文|小张
编辑|小张
前言
根际是附着在植物根系上,或位于其附近的土壤,是微生物活动和多样性的热点。
了解根际微生物群的分类和功能组成,以及它们 与土壤微生物群的区别 ,是至关重要的。
而其中真菌群落,对植物的影响极大,以朝鲜淫羊藿为代表探究一下,土壤内的真菌群落,会对朝鲜淫羊藿的叶片和根际,产生什么影响?

什么是真菌
真菌是根际中高度多样化和活跃的微生物群之一,包括对植物生长、营养和健康有正面和负面影响的物种。
植物可以通过分泌光合产物和根系分泌物,来主动形成和选择根际真菌群落。植物根分泌物的数量和类型,以及植物根的形态是物种特异性的,并有助于植物物种特性,对真菌群落的影响。
周围的大块土壤(即不与植物根紧密接触的土壤)充当真菌的繁殖体库,其可能被生长的植物根选择。真菌群落的多样性、组成和功能 也受到土壤-植物区室的影响。

这种植物通过从根部释放分泌物,来主动招募微生物,这些微生物可以进一步转移到浆果上,从而深刻影响浆果的质量,因此,根际土壤真菌群落的变化,影响着作物的产量和品质。
真菌内生菌通常无症状地感染宿主植物,并存在于活植物的组织内。一些内生真菌通过增强宿主植物,对非生物和生物的重音。

目前,对内生真菌的 生物多样性、化学和代谢物生物活性 进行了大量的研究,以了解内生真菌与其宿主植物之间的关系。
虽然关于可培养内生群落,是否季节性变化的信息很少,但现有证据表明这可能发生在植物的根和叶中。
金等内生真菌在根中,的总定殖频率和物种丰富度,高于叶和茎瑞香狼毒长度在中国西北部。
此外,他们发现植物组织中真菌群落的结构,在叶片出现和休眠阶段之间存在显著差异。曾等显示了,根内生真菌多样性的时间变化白芨,与13℃时的富集程度一致,这也符合植物的营养要求。
由此可见,在植物生长的不同阶段,内生和根际土壤真菌群落的变化趋势有一定的规律性。
基于以上研究结果,我们假设银杏根际土壤和叶片中,内生真菌的群落结构朝鲜淫羊藿Nakai, 表现出一种衰落和上升趋势 。
不同类型的环境因子在不同程度上,决定了根际微生物群落;和某种真菌群落,可能在植物根际或叶片中出现或消失。

研究地点和样本收集
朝鲜淫羊藿于2020年5月10日至8月1日,在澳大利亚北部的马格里度村,采集了不同生长阶段(相隔20天)的Nakai叶样品(MY1-5)。
在同一时期,根际土壤样品朝鲜淫羊藿Nakai,是使用“摇动取样法”收集的。简而言之,采样后,根部的大块土壤被移除,样本被运送到冰上的实验室。
然后, 通过摇动从根部除去松散的土壤,并用无菌刷除去根部的残留土壤。
随后,将从同一广场收集的土壤样品等量混合,在液氮中速冻,并储存在80°c的冰箱中。根据土壤真菌(MT1–5)组进行类似处理。

PCR扩增16S rRNA基因
我们的目标是真菌16SrRNA基因的V3–V4高变区。提取DNA后立即开始PCR。使用2 × Hieff扩增16S rRNA V3–V4扩增子®稳健的PCR主混合物。
使用两种通用的真菌16S rRNA基因扩增子PCR引物(PAGE纯化的):扩增子PCR正向引物和扩增子PCR反向引物。反应设置如下:微生物DNA(10 ng/μl)2μl;扩增子PCR正向引物(10微米)1μl。
扩增子PCR反向引物(10微米)1μl;2 ×希夫®稳健的PCR主混合物(Yeasen,10105ES03,中国)(总共30 μl)。

将板密封,并在热仪器中 使用以下程序进行PCR :95℃变性3分钟的1个循环,95℃变性30秒的前5个循环。
45℃退火30秒,72℃延伸30秒,然后95℃变性30秒、55℃退火30秒、72℃延伸30秒的20个循环,最后72℃延伸5分钟。
用溴化乙锭(EB)染色的TBE缓冲液(Tris、硼酸、EDTA)中的1% (w/v)琼脂糖凝胶电泳检查PCR产物,并在紫外光下观察。

16S rRNA基因文库构建、定量和测序
我们使用AMPure XP珠来纯化扩增子产物中的,游离引物和引物二聚体。使用universal Illumina适配器和index将样品运送至Sangon BioTech(上海)用于文库构建。
测序前,使用量子位测定每个PCR产物的DNA浓度®4.0绿色双链DNA分析, 使用生物分析仪进行质量控制。
根据覆盖范围的需要,可以将所有的库集中起来运行一次。基于它们的浓度,以等摩尔比汇集来自每个反应混合物的扩增子。根据制造商的说明,使用Illumina MiSeq系统进行测序。

测序后,根据重叠用PEAR软件将两个简短的Illumina读数组合起来,并处理fastq文件以产生单独的fasta和qual文件,然后可以用标准方法进行分析。
使用Usearch软件将有效标签聚类到相似性≥ 97%的操作分类单元(OTUs)中。
移除嵌合序列和单一otu(只有一个读数),之后基于otu将剩余序列分类到每个样品中。具有最高丰度的标签序列被选为每个聚类中的代表性序列。
真菌OTU代表序列通过分别对照RDP数据库,和联合真菌ITS数据库进行分类。

微生物组的数据统计分析
α多样性指数(包括Chao1、Simpson和Shannon指数)根据OTU丰富度进行量化。为了评估样本的充分性,我们构建了观察到的otu数量的稀疏曲线。所有α多样性指数用Mothur软件OTU稀疏曲线,和秩丰度曲线在R中绘制。
为了估计样本中微生物群落的多样性,我们通过T检验计算了两组的样本内(α)多样性,并使用ANOVA进行了多组比较测试。
β多样性评估样品中微生物组的差异,通常与主坐标分析(PCoA)、非公制多维标度(NMDS)或约束主成分分析(PCA)等降维方法结合使用,以获得可视化表示。

使用R vegan软件包对这些分析进行可视化,最终样本间距离以散点图的形式呈现。差异比较用于使用STAMP,LEfSe和GraPhlAn软件版本。
相关系数和p- 使用SparCC计算群体/otu之间的值 ,相关矩阵热图用R corrplot软件包用于构建网络图。

物种注释和阿尔法多样性分析
使用Illumina MiSeq系统对总共十个复合样品进行了高通量测序,包括五个根际土壤真菌(MT1–5)和五个叶内生真菌(MY1–5)样品(每个样品有三个生物重复)。
总共1,700,991个原始读数,其中根际土壤真菌987,902个读数(平均每个样品197,580个读数),叶内生真菌711,398个读数(平均每个样品142,279个读数)。
基于在分析样品中检测到的最少数量的序列,我们随机选择并比较了每个样品的根际土壤真菌和叶内生真菌的288,425和229,301个读数。

根据土壤真菌的5个类群(MT1-5)*共中**鉴定出674个操作分类单元,占总操作分类单元的13.71%。MT1、MT2、MT3、MT4和MT5分别包含310、297、145、447和475个otu。
此外,在5组叶片内生真菌(MY1-5)*共中**鉴定出96个OTUs,占OTUs总数的3.27%。MY1、MY2、MY3、MY4和MY5分别含有217、104、165、384和548个otu。
从所有10组样品中获得的OTUs,从门到属水平进行了注释,除去未分类的OTUs,根际土壤真菌*共中**鉴定出16门57纲341科935属;叶内生真菌*共中**鉴定出 16门57纲341科935属 。

为了确定产生的测序数据量是否合理,我们通过绘制提取的数据量(y轴)与α多样性指数(x轴)来构建稀释曲线,α多样性指数反映了样品中给定物种的丰度和多样性。
使用Mothur软件确定α多样性指数;使用ACE和Chao1指数估计社区中otu的数量。
使用香农指数测定样品中的微生物多样性,香农指数通常与辛普森多样性指数一起使用,以反映阿尔法多样性指数。Shannon指数越大,群落多样性越高。相反,辛普森指数越大,群落多样性越低。
ACE、Shannon和Chao1指数的值表明,根际土壤微生物的多样性、丰富度和OTU数在干旱前期先增加后减少朝鲜淫羊藿Nakai生长,而叶片内生真菌的生长则先下降后上升。

优势种相对多度与共线性的相关性
数字3a显示了MT组中门级的微生物种类组成,和相对丰度(平均相对丰度> 1%)。除去未分类的和其他的,这5个MT类群主要由属于该门的真菌组成子囊菌门,担子菌门,被孢霉门,和真菌门。
前三个门代表核心真菌群落。尽管被孢霉门在5个阶段均占优势,其相对多度随时间的延长, 而逐渐降低朝鲜淫羊藿仲井生长期。
在MT1和MT5中,担子菌门是最主要的门(分别占38.29%和74.18%),其次是子囊菌门和被孢霉门。
在MT2、MT3和MT4中,子囊菌门是最主要的门,其次是担子菌门和被孢霉门。此外,壶菌是MT3中唯一相对丰度大于1%的门,而其他门的相对丰度小于1%。球囊霉门是MT4阶段的优势门。

不同菌群和差异表达基因的分析
LEfSe用于确定最能解释不同生物条件,或环境下两组或多组样品之间差异的,遗传或功能特征,以及这些特征影响组间差异的程度。
MT1阶段的主要真菌群落;丛球孢菌,古生菌属。以及瑞士乳杆菌在MT2阶段;枝藻属。克努菲亚和外瓶霉在MT3阶段;
Discosia sp ., Hydnobolites sp,以及刚毛藻。在MT4阶段;和Ramularia, 癸二酸单胞菌,以及吉纤维素菌,在MT5阶段。
的物种丰富性癸二酸单胞菌, MT3显著高于MT1和MT2,比MT4略有下降 。MT5组表现出最高的物种,丰富度癸二酸单胞菌。

笔者观点
笔者认为 ,朝鲜淫羊藿Nakai根际土壤和叶片,在生长过程中具有高度多样化的真菌群落。根际阶段土壤真菌的相对丰度高于生长初期的,叶片内生真菌,但总体丰度基本相当。
皮脂腺是一个明显不同的真菌属癸二酸单胞菌,存在于根际土壤中的叶真菌种类中,朝鲜淫羊藿仲井真,癸二酸单胞菌,根际土壤中的真菌和叶片内生菌可以相互移动。
分析表明,可溶性盐、全氮、碱解氮、全磷、全钾和速效钾是根际土壤和叶片内生真菌有用的环境因子:钾、全氮、全磷和三个环境因子与根际土壤,和叶片内生真菌的相对丰度呈显著正相关。
参考文献
